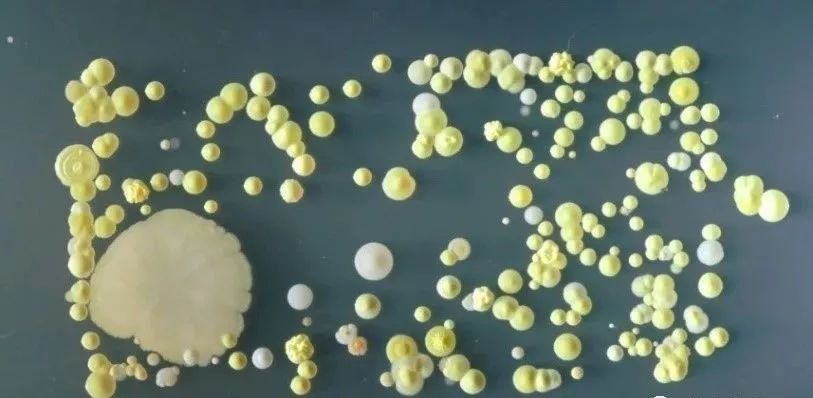
到无害的金葡萄球菌,微球菌,酵母菌,莫拉氏菌和芽孢杆菌,经常是二三十

酵母菌芽孢

求教——酵母菌芽孢相关问题
图片尺寸500x400
酵母和芽孢
图片尺寸1000x1000
酵母菌 霉菌分生孢子 8
图片尺寸1080x810
p>芽孢(endospore)又称 a href="#" data-lemmaid="7279164">内生
图片尺寸800x600
芽孢
图片尺寸220x218
生产发酵饲料的菌种很多,主要有以下四类:乳酸菌,芽孢菌,酵母菌和霉菌
图片尺寸782x568
产风味物质微生物有酵母菌,芽孢杆菌等,酵母代谢产生乙醇,乳酸菌产生
图片尺寸1080x1117
芽孢
图片尺寸466x426
科学小知识酵母菌的出芽生殖
图片尺寸2389x1239
细菌|酵母菌|em|兰氏|芽孢_网易订阅
图片尺寸340x245
摘要:酵母菌是子囊菌,担子菌等几科单细胞真菌的通称,一般泛指能发酵
图片尺寸650x420
优水菌采用的是多种枯草芽孢杆菌,地衣芽孢杆菌光合细菌,酵母菌,及多
图片尺寸1200x784
枯草芽孢杆菌,蜡样芽孢杆菌,地衣芽孢杆菌,凝结芽孢杆菌等.
图片尺寸1080x725
酵母菌的形态
图片尺寸221x220
到无害的金葡萄球菌,微球菌,酵母菌,莫拉氏菌和芽孢杆菌,经常是二三十
图片尺寸813x398
否 型号 生物好氧菌 货号 kj08 品牌 康军 化学成份 芽孢杆菌,酵母菌
图片尺寸790x1805
细菌芽孢染色及酵母菌的观察
图片尺寸558x741
实验八 酵母菌形态观察ppt
图片尺寸1080x810
这个平板培养的是芽孢杆菌. 平板在四度冰箱 封口膜封口后两个多月 成
图片尺寸600x800
枯草芽孢杆菌 巨大芽孢杆菌 蜡样芽胞杆菌 硝化细菌 酵母菌很多
图片尺寸404x300